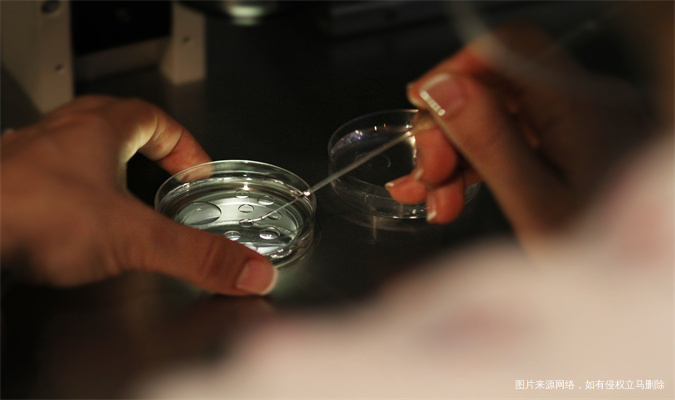

随着科技的进步和医疗条件的改善,试管婴儿技术已成为许多不孕不育家庭实现生育梦想的重要途径。而泰国RFG医院作为该领域的佼佼者,以其先进的技术、专业的医疗团队和较高的成功率吸引了众多国内外患者的关注。本文将重点探讨在泰国RFG医院进行试管婴儿选择男女的费用以及这一技术的准确率。
一、泰国RFG医院试管婴儿选择男女的费用
1、关于泰国RFG医院试管婴儿选择男女的具体费用,由于医疗服务的价格受多种因素影响,包括医院政策、患者个人情况、治疗方案的复杂程度等,因此无法给出确切的固定金额。但根据公开发布的信息和行业内的一般情况,可以提供一个大致的费用范围。
2、泰国RFG医院或其他泰国医院进行试管婴儿的总体费用大致在15万至50万元人民币之间。这一费用涵盖了从初步检查、药物费用、手术费用(包括促排卵手术、取卵手术、胚胎移植手术等)、胚胎培养与检查、胚胎保存等多个环节。特别地,如果涉及性别选择技术,可能会增加一定的费用,但具体增加多少需要根据医院的具体定价和患者的具体情况来确定。
3、泰国RFG医院普遍采用第三代试管婴儿技术,这项技术相比前两代试管费用要高一些,但能够提供更高的成功率和更多的选择空间,包括性别选择。第三代试管婴儿技术不仅可以解决不孕不育问题,还可以通过基因筛查诊断技术检测染色体及遗传性疾病,保障宝宝的健康,并满足家庭个性化生育需求。
二、泰国RFG医院试管婴儿选择男女的准确率
泰国RFG医院在试管婴儿领域取得了令人瞩目的成绩,其试管婴儿的总体成功率达到了70%以上,部分报道甚至指出其三代试管成功率为60%-80%。这一数字不仅高于行业平均水平,也充分反映了医院在试管婴儿技术方面的精湛和专业。
关于试管婴儿选择男女的准确率,它同样受到多种因素的影响,包括患者的年龄、身体状况、治疗方案的选择以及医生的操作水平等。但总体而言,泰国RFG医院凭借其先进的设备和专业的医疗团队,能够在很大程度上提高性别选择的准确率。然而,需要明确的是,性别选择并非百分之百准确,患者在选择时应有充分的心理准备。
总之,泰国RFG医院作为试管婴儿领域的佼佼者,以其先进的技术、专业的医疗团队和较高的成功率吸引了众多患者的关注。在试管婴儿选择男女方面,虽然无法给出确切的固定费用,但可以根据行业内的一般情况和医院的具体定价来估算大致范围。同时,医院在性别选择方面的准确率也相对较高,但并非百分之百准确。如想咨询其它问题,好孕帮将全力支持您的试管婴儿治疗,让您无忧无虑地迎接新生命的到来。











打开APP